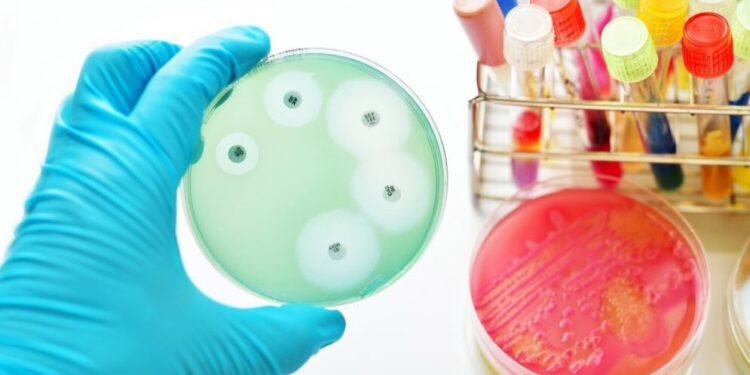
Бактериальный эпсилон токсин, обнаруженный у пациентов с РС, вызывает признаки заболевания РС у грызунов

Новое исследование показало, что рецептор арилуглевода (AHR) может способствовать или “настраивать” перекрестные помехи между микробиомом кишечника и иммунными реакциями, которые были связаны с рассеянным склерозом (РС).
Удаление этого рецептора в наборе иммунных Т-клеток — предполагаемого фактора возникновения и прогрессирования РС — привело к лучшему выздоровлению в модели РС из-за уменьшения воспалительных Т-клеток и изменений в метаболизме микробиома.
По словам исследователей, лечение таурохолевой кислотой, одним из метаболитов, уровень которых был повышен у мышей, лишенных рецептора, или пересадка кала от модифицированных мышей, облегчили тяжесть заболевания РС у животных с нормальной функцией AHR.
“Мы подходим к поиску терапии рассеянного склероза с нового направления”, — сказала Андреа Мерчак, кандидат наук в области неврологии в Университете Вирджинии (UVA) и первый автор исследования, говорится в пресс-релизе университета.
“Модулируя микробиом (совокупность микроорганизмов, которые естественным образом живут внутри нас), мы продвигаемся в понимании того, как иммунный ответ может выйти из-под контроля при аутоиммунитете”, — сказал Мерчак, добавив: “Мы можем использовать эту информацию для поиска ранних вмешательств”.
Изучение связи между микробиомом кишечника и иммунными реакциями
Результаты исследования были подробно изложены в исследовании “Активность рецептора арилуглеводорода в Т-клетках настраивает микроокружение кишечника для поддержания аутоиммунитета и нейровоспаления”, опубликованном в PLOS Biology.
В последние годы была установлена связь между микробами, живущими в кишечном тракте, которые в совокупности называются кишечным микробиомом, и функцией иммунной системы.
Дисбиоз кишечника, нарушение нормального баланса бактерий, грибков и вирусов в кишечнике, наблюдается у пациентов с РС и связан с более ранним началом заболевания и увеличением тяжести заболевания на мышиных моделях заболевания.
Хотя ряд микробных добавок или пробиотиков могут принести пользу, не совсем ясно, как они могут влиять на иммунную функцию.
“Для перевода этих результатов в клинику требуется лучшее понимание перекрестных помех между иммунной системой и микробиомом”, — пишут исследователи.
AHR — это рецептор, участвующий в регуляции передачи сигналов иммунной системы. Этот рецептор, на активность которого могут влиять метаболиты, полученные из микробиома, обнаруживается в меньшем количестве у пациентов с РС. Более того, модуляции AHR у мышей приводят к заметным изменениям микробиома.
Теперь команда исследователей из Центра иммунологии мозга и глии, входящего в состав Медицинской школы UVA, исследовала потенциальную роль AHR в модуляции рассеянного склероза, особенно в отношении микробиома.
В первой серии экспериментов команда использовала здоровых мышей и мышей, генетически модифицированных для отсутствия AHR в CD4-позитивных Т-клетках, типе иммунных клеток, участвующих в РС. Эти животные прошли стандартный протокол, чтобы вызвать заболевание, подобное РС, известное как экспериментальный аутоиммунный энцефаломиелит (EAE).
Результаты показали, что у мышей, у которых отсутствовал AHR, время начала заболевания и пик клинической тяжести были такими же, как у здоровых мышей, но выздоравливали быстрее, чем у здоровых мышей в хронической фазе.
Исследователи отметили, что эта разница в выздоровлении наблюдалась только тогда, когда мутантных мышей содержали отдельно от их здоровых собратьев. Команда отметила, что это, вероятно, было связано с различиями в микробиоме, которые были очевидны только тогда, когда мыши жили отдельно и не влияли на микробиомы друг друга.
У мышей с дефицитом AHR в спинном мозге на этой стадии хронического заболевания было меньше Т-клеток. У мышей также наблюдались соответствующие признаки повышенного апоптоза, типа клеточной гибели, который особенно поражал CD4-положительные иммунные клетки.
Исследователи используют модели мышей, клеточные культуры в лаборатории
Клетки Th17 являются одним из типов CD4-позитивных клеток, которые особенно вовлечены в РС . Когда микробные метаболиты были получены от мышей с дефицитом AHR и добавлены к клеточным культурам здоровых клеток Th17, клетки начали подвергаться апоптозу в большей степени, чем при воздействии метаболитов от здоровых мышей.
Проанализировав микробиом более внимательно, исследователи выявили отчетливый метаболический профиль.
У мышей-мутантов было особенно повышено содержание желчных кислот, причем один из этих метаболитов, таурохолевой кислоты, был в 10 раз выше, чем у контрольных мышей. Эти продукты метаболизма часто обнаруживаются на низком уровне у пациентов с РС, но их добавления в рацион достаточно, чтобы уменьшить тяжесть заболевания на мышиных моделях заболевания.
В клеточных культурах было обнаружено, что таурохолевая кислота индуцирует апоптоз клеток Th17. Более того, когда здоровых мышей лечили таурохолевой кислотой в течение семи дней после индукции EAE, начало заболевания было отсрочено, а пиковые клинические показатели были снижены.
У здоровых мышей, которым пересаживали фекалии от мышей-мутантов, наблюдалось аналогичное, но менее выраженное снижение тяжести заболевания.
Данные в целом указывают на “двунаправленную связь между Т-клетками и микробиомом через AHR”, — пишут исследователи. “По мере того, как мы глубже понимаем сложности использования микробиома кишечника, мы прогнозируем, что инструменты для контроля … модуляции микробов станут новым рубежом для терапии”.
Мерчак отметил, что, хотя пробиотики могут быть сложными для клинического применения из-за их неспецифичности, AHR “может быть легко нацелен на лекарства, поэтому мы, возможно, нашли более надежный путь для поддержания здорового кишечного микробиома”.
“В конечном счете, точная настройка иммунного ответа с использованием микробиома может избавить пациентов от серьезных побочных эффектов иммунодепрессантов”, — заключил Мерчак.